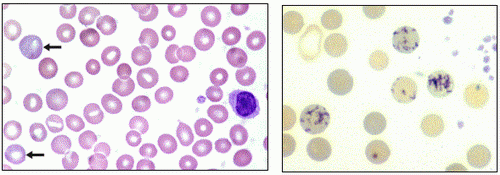

조혈과 혈구생성기관 | |||
|
| |||
|
|
|||
|
구체적 학습목표 1. 조혈모세포와 조혈미세환경의 개념을 설명한다. 참고서적
WebSites
| |||
|
|
|||
|
1. 조혈(Hemopoiesis)의 개념 조혈모세포(造血母細胞, hemopoietic stem cell)는 일정하게 자기복제(self-renewal)와 증식(proliferation)을 계속하여 혈구를 생성하고, 한편으로는 성숙하여(maturation) 일정 생존기간 후 파괴, 소실됨으로서 항정상태(steady state)를 유지한다. 혈액질환이란 이러한 항정상태에 불균형이 일어난 경우라고 할 수 있으며, 항정상태가 깨지면서 혈액세포의 양적. 질적 이상이 초래된다. 즉, 세포의 생성, 세포의 방출 및 세포의 생존기간이 증가(cytosis)하거나 또는 감소(cytopenia)하게 되고 또한 세포의 형태 및 기능에도 이상(dyspoiesis)이 오게 된다. [참고] 간세포(幹細胞) - 학술용어 사용에 관한 의견
| |||
|
2. 조혈모세포(Hemopoietic Stem Cells) 1) 특징: 자기복제로 존속하면서, 한편으로는 증식(proliferation)과 분화(differentiation)를 한다. 2) 분류
(2) Colony-Forming Units-Granulocytes, Erythrocytes, Macrophages and Megakaryocytes (CFU-GEMM) : 다능성 조혈성장인자인 IL-3를 첨가한 세포배양계에서 형성되는 세포집락은 과립구계, 적혈구계, 거핵구계 미성숙세포로 구성된다. 이러한 세포집락을 형성할 수 있는 조혈모세포가 CFU-GEMM이며, CFU-S와 거의 같은 분화단계의 세포이다. (3) Erythroid-committed Stem Cells (CUF-E, BFU-E) : 골수세포를 erythropoietin과 함께 상체외배양(in vitro culture)하면 적혈구계 세포집락이 형성되는데 생성되는 양상에 따라 두 종류로 나눌 수 있다. ① Burst forming unit-erythroid (BFU-E): 다량의 erythropoietin이 필요하며 세포배양 14일경에 적혈구계의 큰 세포집락(bursts)을 형성한다. (4) Granulocyte and Monocyte-committed Stem Cells (CFU-GM, CFU-NM) (5) Megakaryocyte-committed Stem Cells (CFU-MEG, CFU-MK)
| |||
|
3. 조혈성장인자 (造血成長因子, Hemopoietic Growth Factors, Hemopoietin, Cytokines) 혈구생성은 골수내 간질세포(間質細胞, stromal cells)와 조혈성장인자(造血成長因子, hemopoietic growth factor), 다양한 세포외 기질(extracellular matrix)로 구성된 조혈미세환경(造血微細環境, hemopoietic microenvironment)에 의해 조절되고 영향을 받는다. 세포외 기질은 fibronectin, hemonectin, laminin, collagen, proteoglycan 같은 단백이 주요성분이며, 조혈성장인자로는 IL-3, GM-CSF, G-CSF, M-CSF 등인데 대부분 대식세포(macrophage), 내피세포(endothelial cell), 섬유아세포(fibroblast)와 같은 간질세포에서 분비된다. 적혈구생성(erythropoiesis)은 신장에서 분비되는 erythropoietin에 의해 조절되는데, erythropoietin은 CFU-E가 proerythroblast로 분화할 때 작용하며 proerythroblast가 망상적혈구로 성숙하는데 시간도 단축시킨다.
| |||
|
4. 태아에서의 조혈 (embryo and fetal hematopoiesis) 1) 중아세포기(mesoblastic period) 2) 간성조혈기(hepatic hemopoiesis) 3) 골수조혈기(medullary hemopoiesis)
| |||
|
5. 골수의 구조와 기능 1) 골수의 구조 출생시에는 골수가 유일한 조혈기관이며 4세까지는 거의 모든 골수강(marrow cavity)에 지방세포가 거의 없는 적색골수이다. 그러나 성인이 되면 두개골, 늑골, 흉골, 견갑골, 쇄골, 척추골, 골반, 상완골과 대퇴골 일부에서만 혈구가 생성된다. 또한 이들 조혈기관의 골수도 약 50%는 지방조직으로 대치되어 있다. 각종 질환 상태에서 조혈세포가 차지하는 비율 즉, 세포충실도(cellularity)가 변하게 되며(정상 성인은 50%) 간이나 비장과 같은 골수외 조혈(extramedullary hematopoiesis)이 나타날 수도 있다. 골수는 우리 인체에서 가장 큰 장기로서 하루에 적혈구 2천억개씩을 생산하는 아주 활발한 기능을 가지고 있다. 골수는 spongy bone 사이에 있으며 혈관, 신경, 망상세포, 섬유, 지방세포 및 조혈세포(haemopietic cell) 및 림프구를 포함한다.
그림 8. 늑골의 종단면
그림 9. 골수 생검조직의 저배율 사진 A: Bone marrow, B: Bone matrix, C: Skeletal muscle, A: Osteocyte B: Hemopoietic cells 혈관은 다른 장기에서와 같이 소동맥, 동맥모세혈관, 정맥동(sinusoid), 정맥으로 구분할 수 있는데 영양동맥(nutrient artery)이 뼈를 뚫고 들어와 소동맥으로 나누어진다. 이들 소동맥의 일부는 뼛속으로 다시 들어갔다가 나와 모세혈관이 되어 골수에서 가장 중요한 구조인 정맥동이 된다. 이 정맥동이 모여 정맥을 이루고 이는 동맥이 들어온 길과 나란하게 뻗어 골수를 벗어난다. 골수에서 림프관이 없고 신경은 혈관을 따라 들어간다. 소동맥 주위에서는 과립구가 생성되고 때로는 형질세포가 모여 있다. 정맥동 주위에서는 거핵구와 적혈구들이 만들어진다. 또한 골수에서 생성된 세포가 말초혈액으로 나가는 장소가 이 정맥동이다. 그러므로 정맥동 주위에서는 성숙된 세포들이 모여있어 빠져나갈 순서를 기다리고 있게 된다.
골수내 각 구조물의 정상적인 분포 Hemopoietic compartment : packed with myelocytes, erythroblasts, promonocytes, et al 2) 골수의 기능 (1) 적혈구 생성(erythropoiesis) Proerythroblast → Basophilic Erythroblast → Polychromatophilic E. → Orthochromatophilic E. → (Reticulocyte) → Erythrocyte(RBC)
그림 10. 골수내 분화 성숙단계의 유핵적혈구(적아구)
그림 11. 다염색성 적혈구 Polychromatic RBCs = Young RBC, Reticulocyte (0.5-1.5%) 적아구(erythroblast)는 정아구(normoblast)와 같은 뜻으로 사용된다. 적아구는 분화되면서 크기는 작아지고, 세포질과 핵의 비율(N:C ratio)이 증가하며, ribosomal RNA가 감소하면서 혈색소 양은 풍부해진다. 비효율적 적혈구 생성(ineffective erythropoiesis)이라 함은 골수내에서 적혈구 전구세포가 성숙적혈구로 분화하지 못하고 사멸되는 현상이며, 이들 세포는 대부분 대식세포(macrophage)에 의해 탐식 처리된다. (2) 과립구와 단구 생성(granulocytopoiesis, monocytopoiesis) → CFU-GM → CFU-G → Myeloblast → Promyelocyte → Myelocyte → Metamyelocyte → Band Neutrophil → Seg. Neutrophil
CFU-M → Monoblast → Promonocyte → Monocyte → Macrophage (mononuclear phagocytic system)
그림 12. 골수내 분화 성숙단계의 중성구계 선조세포 전골수구는 아주르호성 과립(azurophilic granules) 또는 일차과립(primary granules)이라 불리는 부속물을 갖고, 골수계 세포의 분화단계에서는 가장 큰 세포이다. 골수구 단계에서는 소수의 아주르호성 과립이 나타나지만 특이 과립(specific, neutrophilic, secondary granules)로 대치된다. 후골수구 단계에서는 핵 모양이 "C" 또는 "U"자형(kidney, bean-shaped)으로 변하며, 분절형(segmented) 중성구는 2-5개의 엽(葉, lobe)을 가진다. (3) 혈소판 생성(thrombocytopoiesis) (4) 골수검사 【실시부위】 1) 후장골능(posterior iliac crest) : 모든 연령층에서 골수생검과 천자 【준비물】 골수천자만을 위해서는 Illinois needle가 사용되기도 하지만, 통상 Jamshidi Bone Marrow Biopsy/ Aspiration needle로 천자와 생검을 실시한다. 고정액으로는 10% formalin을 사용하고 각종 세포화학검사(cytochemistry)를 실시할 경우에는 그에 해당하는 고정액을 준비하여야 한다. 염색체검사나 세포배양이 필요할 경우는 보존제가 첨가안된(preservative-free) heparin tube도 준비한다.
그림 14. 골수천자용 Illinois Needle(왼쪽)과 Jamshidi BM Aspiration/Biopsy Needle(오른쪽) 골수천자 도말과 생검조직 표본은 각각 Wright 염색과 H&E 염색을 시행하였다.
【적응증】
| |||
|
6. 비장의 구조와 기능 | |||
|
1) 비장의 구조
2) 비장의 기능 ① Culling: 오래된 혈구를 제거 ② Pitting: 적혈구내 부속물(inclusion) 제거 (3) 체내 철 재활용(Iron reutilization) ① 태생 5개월까지 조혈 ② 골수양화생(myeloid metaplasia) [2004년 3월29일] |
http://kdcp.hallym.or.kr/education/hemopoiesis1.htm